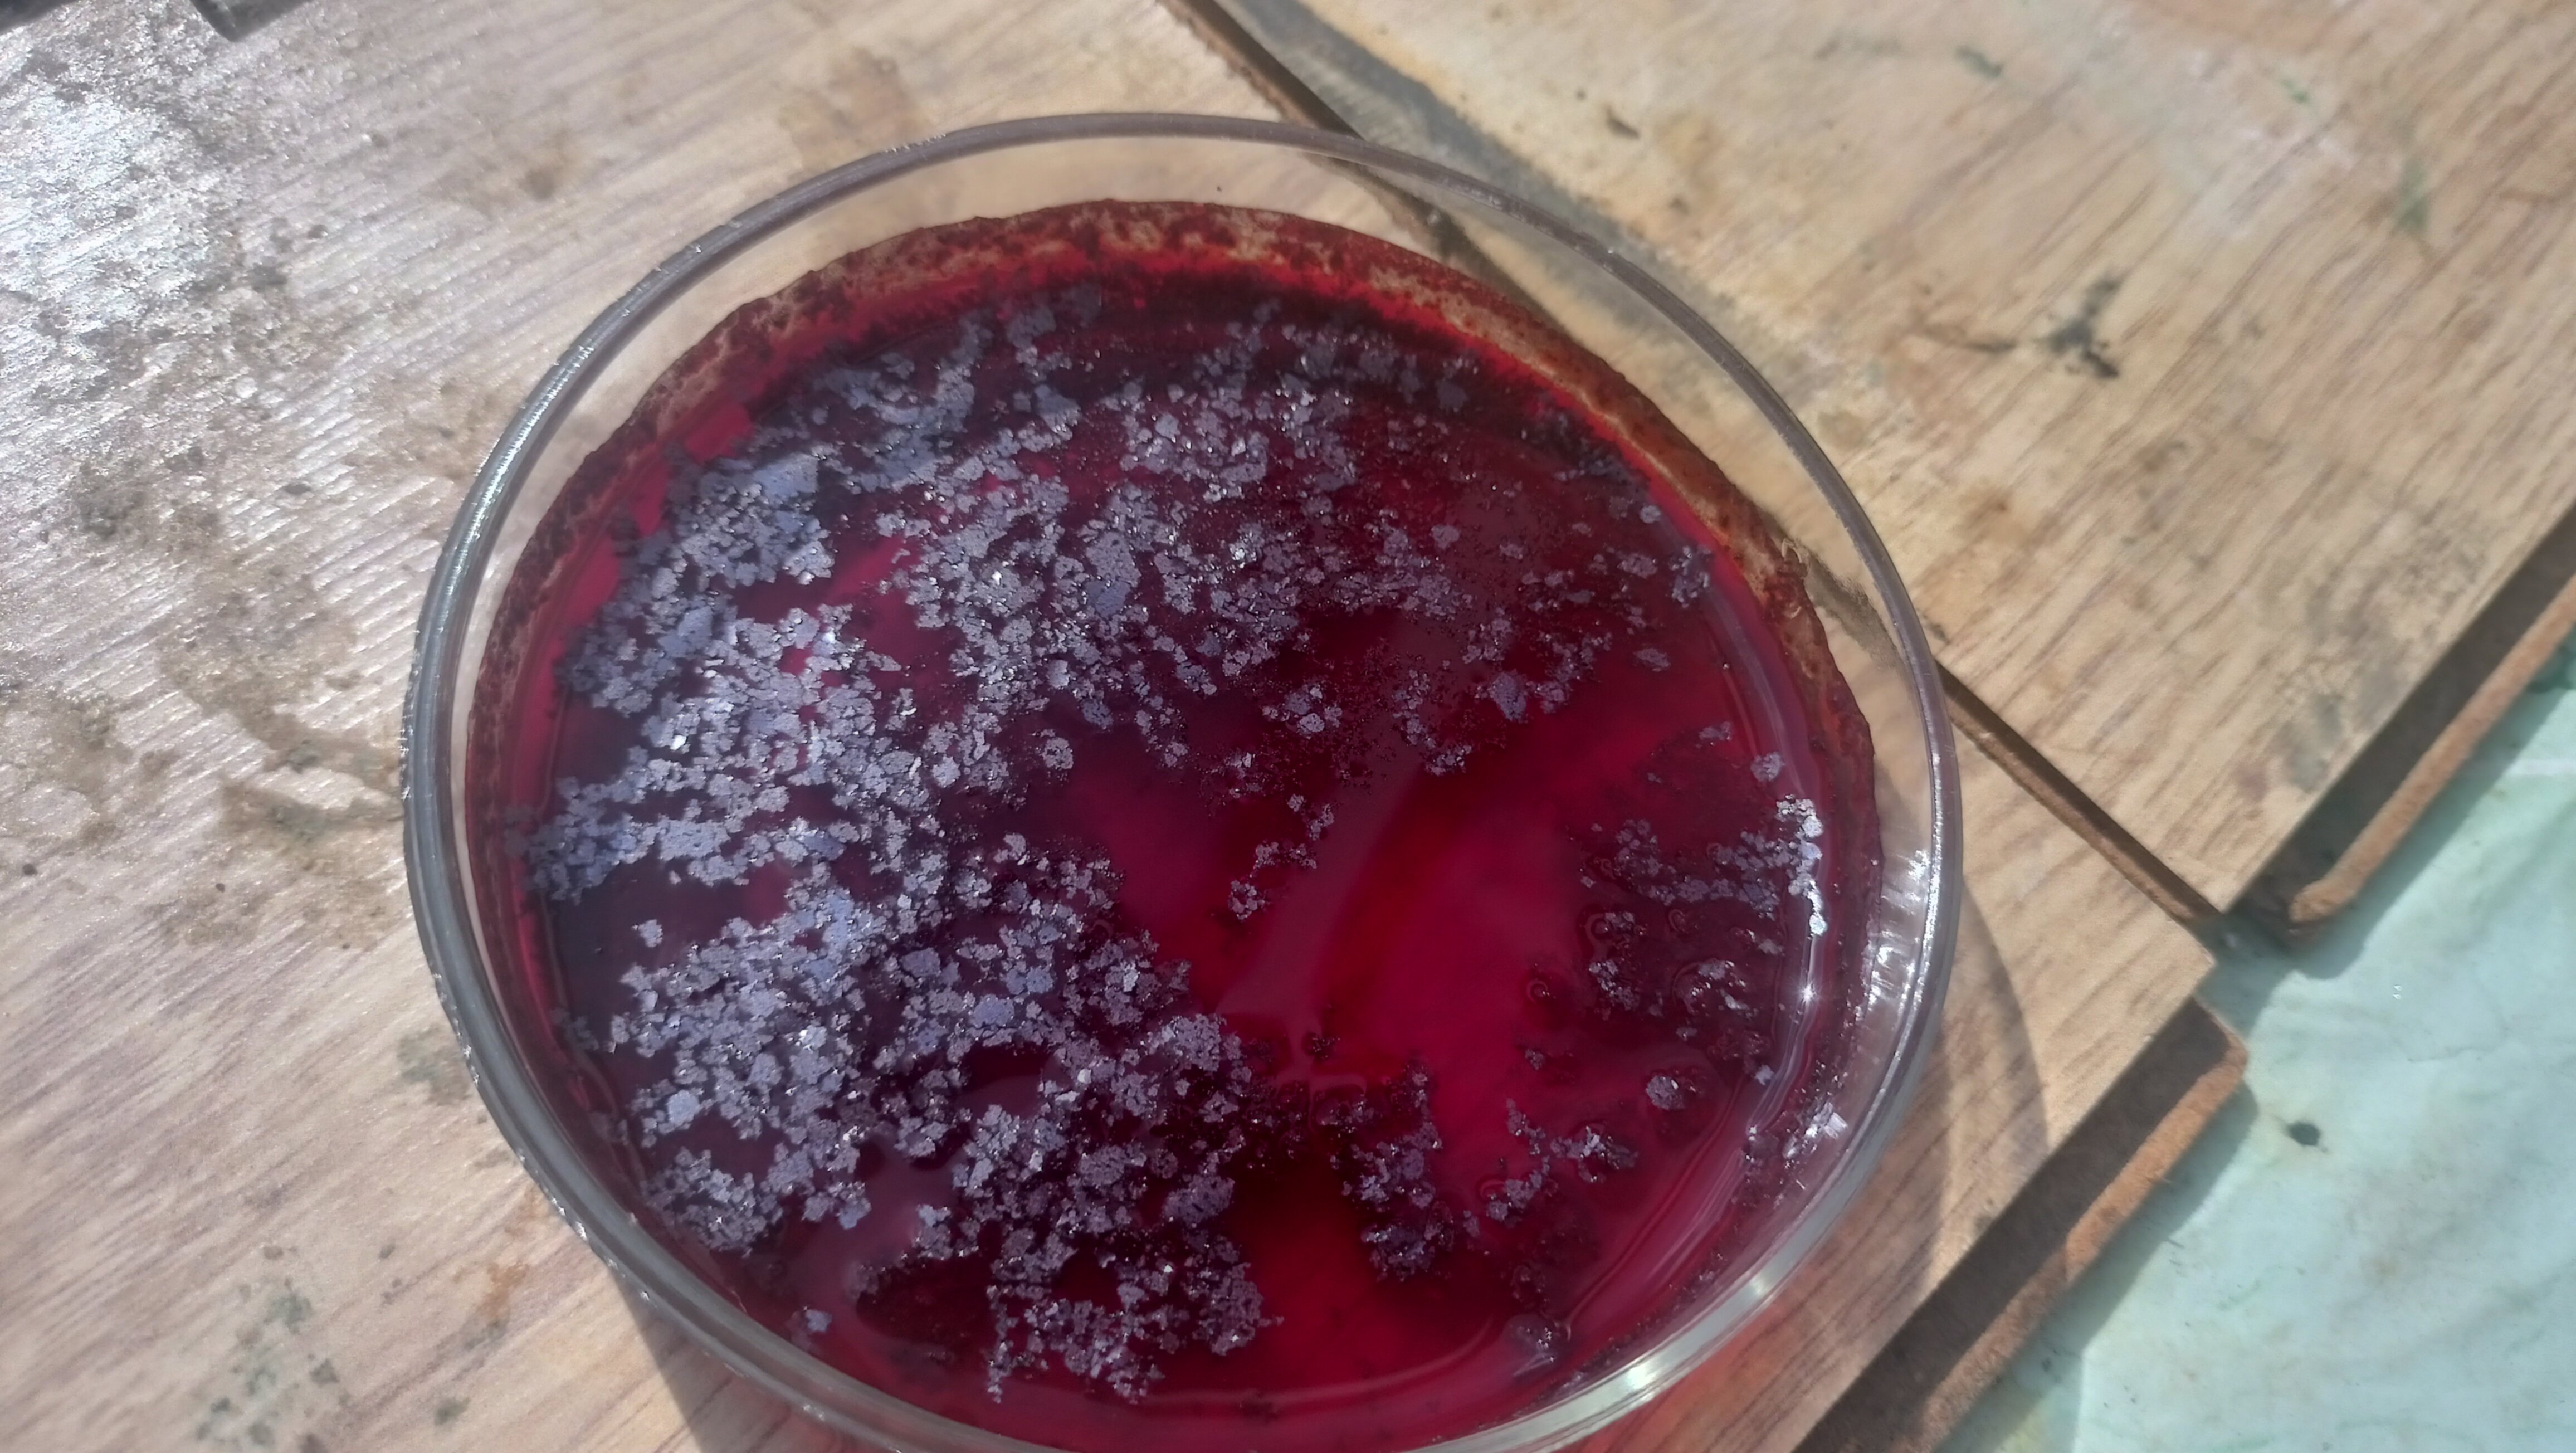

02 May 2025 - me :3
Pyrylium is a six-membered oxygen-containing heterocycle that is quite commonly encountered in compounds derived from plants and also in dyes, with its derivatives having some uses in synthesis of heterocyclic compounds like pyridines and phosphines. Usually pyrylium salts are prepared from intermolecular condensations of aromatic aldehydes, for example the commonly encountered 1,3,5-triphenylpyrylium salt prepared from acetophenone and benzaldehyde, however, the salt described next is prepared via an intramolecular condensation, entailing a slightly different procedure.
This particular pyrylium salt was synthesized in 19081 as part of an attempt of making synthetic coumarines, which wasn’t very successful. While they failed at making coumarines during the research of this particular compound, the synthesis of these salts has lead to the discovery of a very peculiar type of structure - the spiropyran.

The spiropyran generated from this salt is not photochemically or thermochemically interesting, so I decided to explore the chemistry of the pyrylium salt instead, as the structure looked quite curious to me.
For learning more about spiropyran history, one should refer to the paper by Luuk Kortekaas and Wesley R. Browne (2019), as it is the work that has brought this compound and its historical value to my attention
The synthesis of this compound is quite simple, starting with an Aldol (more accurately a Claisen–Schmidt condensation) to form the ketone precursor followed by an acid-catalyzed condensation of the ketone into the final product. Aftewards it is possible to run a condensation reaction to condense it further into the benzospiropyran, but I have chosen to avoid doing that because of a lack of motivation. :(

On my first attempt I didn’t pay much attention to literature, and just tried blindly copying the steps for the synthesis of Dibenzalacetone from Orgsyn2. This has proven to be a mistake. As the final product was a salt and considerably more soluble in water, making its isolation much harder.

2 grams of sodium hydroxide were dissolved in 20 ml of water and 20 ml of methanol, to which 2.4 grams of salicylaldehyde (0.02 mol) and 0.58 grams of acetone (0.01 mol) were added with vigorous stirring. Over time the reaction mixture turned red and no product precipitation was observed. At this point the solution was set to slowly evaporate on a slightly warm hotplate overnight. A reasonable amount of crystalline precipitate was still obtained but was all set aside, as I wanted to carry out the synthesis in a much more proper manner.
This time, I have changed up the procedure slightly and made it more accurate to the one carried out in the old german paper1, paying closer attention to the high acidity of the resulting product.
2.4 grams of salicylaldehyde and 0.6 grams of acetone were dissolved in 10 milliliters of methanol. A solution of 1.6 grams of sodium hydroxide in 5 ml of water was poured into the methanolic reaction mix with intense stirring. The solution was left to stir and evaporate at room temperature. After a short while a colour change from transparent to orange-red has occured, and on the next day a crop of dark red-brown crystals was obtained.

The disodium salt of dicoumarketone is a red-brown crystalline solid that dissolves in water to give strongly coloured red solutions. This property lead to a quite grim looking gravity filtration.

To the delight of a few quite unwell girl-adjacent entities3 4, getting this product on my skin quite accurately resembled getting bloodstains all over my hands.

The Dicoumarketone disodium salt was then dissolved in 50 ml of distilled water, and 0.8 ml of glacial acetic acid were added to precipitate out the insoluble free acid. This is actually unrecommended, as acetic acid is too strong, and literature suggests bubbling CO2 through it instead. (setting up a CO2 generator was way too much for me, already beaten by blackouts and summer heat).

My laziness has directly lead to a decreased yield, so it’s worth trying this with a weaker acid instead. The yield of the free acid was 1.42 grams, which corresponds to ~50% of theoretical. Quite bad for such a simple reaction.
An attempt of dissolving the free acid in methanol was attempted, however some kind of insoluble impurity (perhaps from the acid sitting out for a bit too long) was present, and had to be filtered away. This was not present in the test run and could possibly be attributed to getting a worse purity material during the precipitation, so it may be preferable for the acid to be precipitated out from more dilute solutions and with a weaker acid.
The obtained yellow-brown clear solution was then acidified with a few drops of concentrated hydrochloric acid and left to evaporate in a dish, resulting in a formation of a bright red solution and crystals.
The product was scraped off the dish and weighed out, giving us a miserable 0.47 grams of the salt.

I am not quite sure of the purity of the final product, as the procedure for properly crystallizing the pyrylium hydrochloride salt is quite more complex5 (involving formic acid saturated with hydrogen chloride). There are also some interesting sounding adducts with metals, which I might or might not prepare at some point.